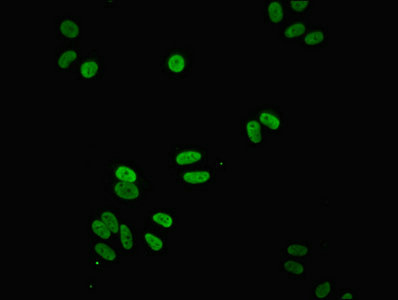

NDUFS3 Antibody
-
中文名稱:NDUFS3兔多克隆抗體
-
貨號:CSB-PA015662ESR1HU
-
規格:¥440
-
圖片:
-
Western blot
All lanes: NDUFS3 antibody at 1.98μg/ml
Lane 1: Mouse brain tissue
Lane 2: Mouse skeletal muscle tissue
Lane 3: Mouse heart tissue
Secondary
Goat polyclonal to rabbit IgG at 1/10000 dilution
Predicted band size: 31, 15 kDa
Observed band size: 31 kDa -
Immunohistochemistry of paraffin-embedded human kidney tissue using CSB-PA015662ESR1HU at dilution of 1:100
-
Immunohistochemistry of paraffin-embedded human heart tissue using CSB-PA015662ESR1HU at dilution of 1:100
-
Immunofluorescent analysis of HepG2 cells using CSB-PA015662ESR1HU at dilution of 1:100 and Alexa Fluor 488-congugated AffiniPure Goat Anti-Rabbit IgG(H+L)
-
-
其他:
產品詳情
-
產品名稱:Rabbit anti-Homo sapiens (Human) NDUFS3 Polyclonal antibody
-
Uniprot No.:
-
基因名:
-
別名:CI 30 antibody; CI 30KD antibody; CI-30kD antibody; Complex I 30KD antibody; Complex I 30kDa subunit antibody; COMPLEX I, MITOCHONDRIAL RESPIRATORY CHAIN, 30-KD SUBUNIT antibody; Complex I-30kD antibody; mitochondrial antibody; NADH coenzyme Q reductase antibody; NADH dehydrogenase (ubiquinone) Fe S protein 3 30kDa antibody; NADH dehydrogenase [ubiquinone] iron sulfur protein 3 mitochondrial antibody; NADH dehydrogenase [ubiquinone] iron-sulfur protein 3 antibody; NADH dehydrogenase ubiquinone 30 kDa subunit antibody; NADH-ubiquinone oxidoreductase 30 kDa subunit antibody; NADH-Ubiquinone Oxidoreductase Fe-S Protein 3 antibody; NDUFS3 antibody; NDUS3_HUMAN antibody
-
宿主:Rabbit
-
反應種屬:Human, Mouse
-
免疫原:Recombinant Human NADH dehydrogenase [ubiquinone] iron-sulfur protein 3, mitochondrial protein (37-264AA)
-
免疫原種屬:Homo sapiens (Human)
-
標記方式:Non-conjugated
-
克隆類型:Polyclonal
-
抗體亞型:IgG
-
純化方式:Antigen Affinity Purified
-
濃度:It differs from different batches. Please contact us to confirm it.
-
保存緩沖液:PBS with 0.02% sodium azide, 50% glycerol, pH7.3.
-
產品提供形式:Liquid
-
應用范圍:ELISA, WB, IHC, IF
-
推薦稀釋比:
Application Recommended Dilution WB 1:500-1:2000 IHC 1:20-1:200 IF 1:50-1:200 -
Protocols:
-
儲存條件:Upon receipt, store at -20°C or -80°C. Avoid repeated freeze.
-
貨期:Basically, we can dispatch the products out in 1-3 working days after receiving your orders. Delivery time maybe differs from different purchasing way or location, please kindly consult your local distributors for specific delivery time.
-
用途:For Research Use Only. Not for use in diagnostic or therapeutic procedures.
相關產品
靶點詳情
-
功能:Core subunit of the mitochondrial membrane respiratory chain NADH dehydrogenase (Complex I) which catalyzes electron transfer from NADH through the respiratory chain, using ubiquinone as an electron acceptor. Essential for the catalytic activity and assembly of complex I.
-
基因功能參考文獻:
- identified a novel Leigh syndrome causing NDUFS3 mutation and expanded the clinical spectrum caused by NDUFS3 mutations in this study. PMID: 30140060
- The results suggest that the impaired mitochondrial activity could be due to the broken interaction between DJ-1 and NDUFS3 and that downregulation of DJ-1 in sperm and testes contributes to AS pathogenesis. PMID: 29849492
- The NDUFS3 expressed in the temporal cortex in patient with late-onset Alzheimer's disease. PMID: 28242297
- High NDUFS3 expression is associated with IgA nephropathy. PMID: 25770168
- pH stability of w-t and Leigh syndrome mutant varied at extreme acidic pH. the molten globule like structure of w-t at pH1 was absent in case of the mutant protein. Both the w-t and mutant proteins showed multi-step thermal and Gdn-HCl induced unfolding PMID: 24028823
- NDUFS3 is down-regulated in serous ovarian adenocarcinoma PMID: 23446378
- Expressions of GRIM-19, NDUFS3, and extracellular matrix elements are correlated with invasive capabilities of breast cancer cell lines. PMID: 23630608
- a novel, biomarker potential of a mitochondrial complex I subunit protein, NDUFS3 - as a robust indicator of breast cancer progression and invasiveness as well as of hypoxia/necrosis in clinical specimens of invasive ductal carcinoma, was uncovered. PMID: 21867691
- Decreased protein levels of complex I 30-kDa subunit in fetal Down syndrome brains. PMID: 11771736
顯示更多
收起更多
-
亞細胞定位:Mitochondrion inner membrane; Peripheral membrane protein; Matrix side.
-
蛋白家族:Complex I 30 kDa subunit family
-
數據庫鏈接:
Most popular with customers
-
-
YWHAB Recombinant Monoclonal Antibody
Applications: ELISA, WB, IHC, IF, FC
Species Reactivity: Human, Mouse, Rat
-
Phospho-YAP1 (S127) Recombinant Monoclonal Antibody
Applications: ELISA, WB, IHC
Species Reactivity: Human
-
-
-
-
-